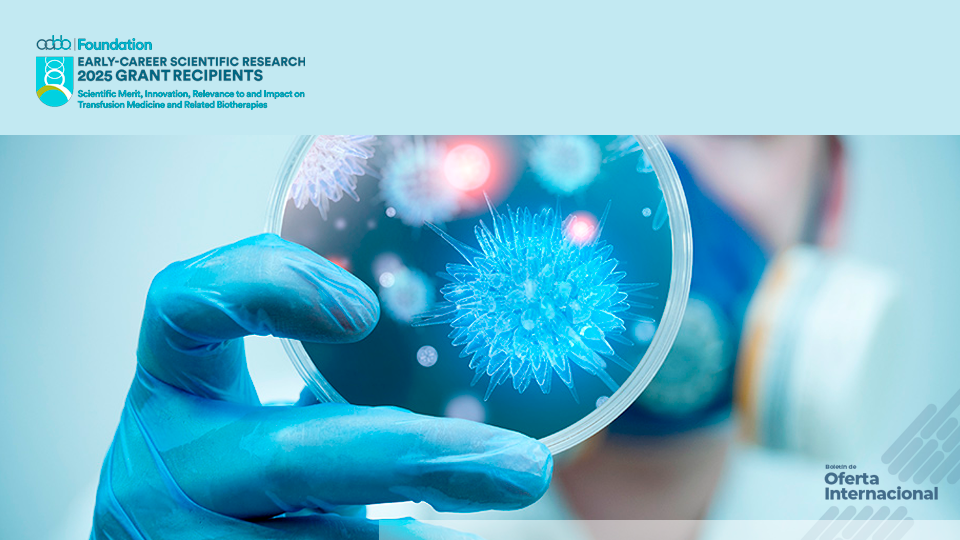
Subvención internacional para investigación en medicina transfusional. AABB Foun

Subvención internacional para investigación en medicina transfusional. AABB Foundation.
Subvención internacional para investigación en medicina transfusional. AABB Foundation.AABB Foundation: Subvención internacional para investigación médica temprana
Fecha de fin:
Categoría: Subvenciones
Dirigida a: Comunidad
Para quienes habitan en una ciudad que no se detiene, donde las ideas nacen a diario y la investigación florece en laboratorios, universidades y hospitales, esta puede ser una oportunidad transformadora. En el #BoletíndeOfertaInternacional te compartimos una convocatoria que abre las puertas a científicas y científicos de Bogotá que están dando sus primeros pasos en el mundo de la investigación biomédica.
Porque en #BogotáMiCiudadMiCasa, el talento no tiene fronteras y la ciencia también se internacionaliza. Hoy, abrimos la puerta a una de las fundaciones más reconocidas en el campo de la medicina transfusional: la AABB Foundation.
🟢 Nombre de la oferta: Early-Career Scientific Research Grants Program – AABB Foundation
🏢 Institución responsable: AABB Foundation (Estados Unidos)
🗓️ Fecha de cierre de la convocatoria: 1 de diciembre de 2025
🎁 Beneficios:
Subvención de hasta USD $100,000
Acceso a redes científicas globales
Posibilidad de publicar y visibilizar resultados
Asesoría por parte del comité científico
Participación en mentorías y reconocimiento académico
🧭 Categoría de la oferta: Subvención
👥 Público objetivo: Para la Comunidad – Investigadoras e investigadores residentes en Bogotá, profesionales de la salud o ciencias biológicas, con título de MD o PhD.
🌐 Modalidad: Virtual (postulación en línea), aplicable desde cualquier país. No requiere residencia en EE. UU.
📌 Detalles específicos de la oferta: Esta subvención está dirigida a personas que se encuentren en las primeras etapas de su carrera investigativa, es decir, quienes hayan terminado su título de doctorado o residencia médica en los últimos 10 años, y que aún no hayan recibido subvenciones mayores como el NIH R01.
El proyecto puede tener una duración de uno o dos años, con un presupuesto máximo de $100,000 USD para todo el periodo. Las áreas de investigación incluyen, entre otras:
Hematología y medicina transfusional
Inmunología e inmunohematología
Bioterapias y medicina regenerativa
Enfermedades infecciosas relacionadas con transfusión
Manejo de sangre en pacientes (Patient Blood Management)
📄 Requisitos:
Contar con un título de MD o PhD o ser tecnólogo/a médico con experiencia investigativa.
Tener menos de 10 años desde la obtención del último grado (o residencia médica).
No haber recibido antes una subvención AABB ni una NIH R01.
Presentar un proyecto original, innovador y que no haya sido financiado previamente.
Se valoran positivamente propuestas con enfoque en nuevas metodologías, tecnologías emergentes o impacto clínico.
🔗 URL oficial: 👉 https://www.aabb.org/foundation/early-career-scientific-research-grants-program
Esta es una de esas oportunidades en las que una idea nacida en un laboratorio de Bogotá puede convertirse en una solución médica global. La AABB Foundation busca precisamente eso: potenciar talentos que están iniciando su camino y que necesitan ese primer impulso para validar datos, generar evidencia y avanzar hacia una carrera científica sólida.
La subvención funciona como una inversión semilla, permitiendo desarrollar proyectos piloto, generar datos preliminares o validar hipótesis con apoyo institucional. Es, en muchos casos, el puente entre la motivación y el impacto real.
📬 ¿Por qué postular desde Bogotá?
Porque Bogotá está llena de talento joven y equipos de investigación que ya trabajan en temas relacionados con salud, biotecnología, inmunología y terapias avanzadas. Esta convocatoria internacional reconoce ese potencial, y lo valora sin importar nacionalidad, religión, género o edad.
Desde la Consejería de Relaciones Internacionales de Bogotá creemos firmemente en el intercambio de conocimientos como motor de desarrollo. #BogotáInternacional no solo se conecta con el mundo: también lo transforma desde lo local.
Si tu trabajo tiene el poder de mejorar vidas, si estás buscando ese impulso que te lleve al siguiente nivel de tu carrera científica, esta es tu oportunidad.
📌 Recuerda: la convocatoria está abierta hasta el 1 de diciembre de 2025. Empieza hoy mismo tu aplicación y prepárate para abrir nuevas puertas con tu investigación.
Este contenido fue creado a partir de la información proporcionada y difundida por AABB Foundation https://www.aabb.org . El artículo fue curado por un o una periodista de la Consejeria de Relaciones Internacionales. Si tienes alguna sugerencia, observación o necesitas más información sobre la nota publicada, puedes hacerlo a través de los canales de atención a la ciudadanía de la entidad mencionada o en Bogotá te Escucha: https://bogota.gov.co/sdqs/.


